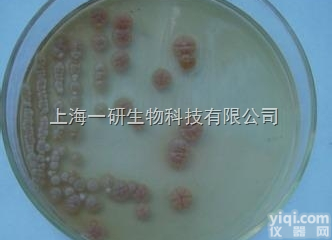
<em>烟色</em>拟<em>多毛</em>盘孢菌操作步骤

烟色拟多毛盘孢菌现货,ATCC菌株
- 品牌:ATCC
- 产地:进口/国产
- 供应商:上海邦景实业有限公司
- 供应商报价:面议
- 标签:烟色拟多毛盘孢菌现货,ATCC菌株,1,上海邦景实业有限公司
| 品牌 | 其他品牌 | 货号 | BJ-JZ1269 |
|---|---|---|---|
| 规格 | 详见瓶身标签 | 供货周期 | 现货 |
| 主要用途 | 科研 |
烟色拟多毛盘孢菌现货,ATCC菌株产品介绍:
资源名称:烟色拟多毛盘孢菌 种属:Pestalotiopsis sp. 分离基物 根提供形式 冻结物安全等级 1模式菌株 no
烟色拟多毛盘孢菌现货,ATCC菌株产品优势:
☆保质保量,我司提供的是ATCC保藏ZX的菌株,权威性高,为世界知名品Pai;
☆价格优惠,我司提供的价格公允,批量订购的客户还会获得相关优惠,咨询;
☆现货供应,供货周期短,当然,客户也可以提前订购,将会获得全新批次的产品;
☆相关服务,我司可提供相关技术服务,为您的科研实验保驾护航。
定期移植保藏法:
1.适用范围:适用于大多数细菌和真菌。
2.原理:低温条件下保藏可减缓微生物菌种的代谢活动,YZ其繁殖速度,达到减少菌株突变,延长菌种保藏时间的目的。
3.技术要求
•不同菌种应根据要求选择合适的培养基。
•接种时要求无菌操作,避免染菌。
•保藏期间要定期检查菌种存放的房间、冷库、冰箱等的温度、湿度,各试管的棉塞有无污染现象,如发现异常应取出该管,重新移植培养后补上空缺。
•大量菌种同时移植时,各菌株的菌号、所用培养基要进行核对,避免发生错误。
•每次移植培养后,应与原保藏菌株和菌株的登记卡片逐个对照,检查无误后再存放。
•斜面菌种应保藏相继三代培养物以便对照,防止因意外和污染造成损失。
4.方法与步骤
(1)器皿准备
(2)溶解培养基配料
(3)调pH值
(4)加凝固剂
(5)过滤分装
(6)包扎标记
将试管加棉塞,外面包扎一层牛皮纸或铝箔并注明培养基名称及配制日期。
(7)灭菌
(8)无菌检查
相关产品:
特价促销 主动脉瓣(可提供标记服务)
特价促销 中性树胶(可提供标记服务)
特价促销 中脑(可提供标记服务)
特价促销 质粒小量提取试剂盒(柱式)(可提供标记服务)
特价促销 植物蛋白抽提试剂(可提供标记服务)
特价促销 直肠肿瘤(可提供标记服务)
特价促销 直肠腺癌组织芯片(可提供标记服务)
进口原装 停靠蛋白1(DOK1)检测试剂盒(酶联免疫吸附试验法)
进口原装 异连蛋白α(DTNα)检测试剂盒(酶联免疫吸附试验法)
进口原装 Dymeclin蛋白(DYM)检测试剂盒(酶联免疫吸附试验法)
进口原装 双氧化酶1(DUOX1)检测试剂盒(酶联免疫吸附试验法)
进口原装 角化不良蛋白(DKC)检测试剂盒(酶联免疫吸附试验法)
进口原装 Dystonin蛋白(DST)检测试剂盒(酶联免疫吸附试验法)